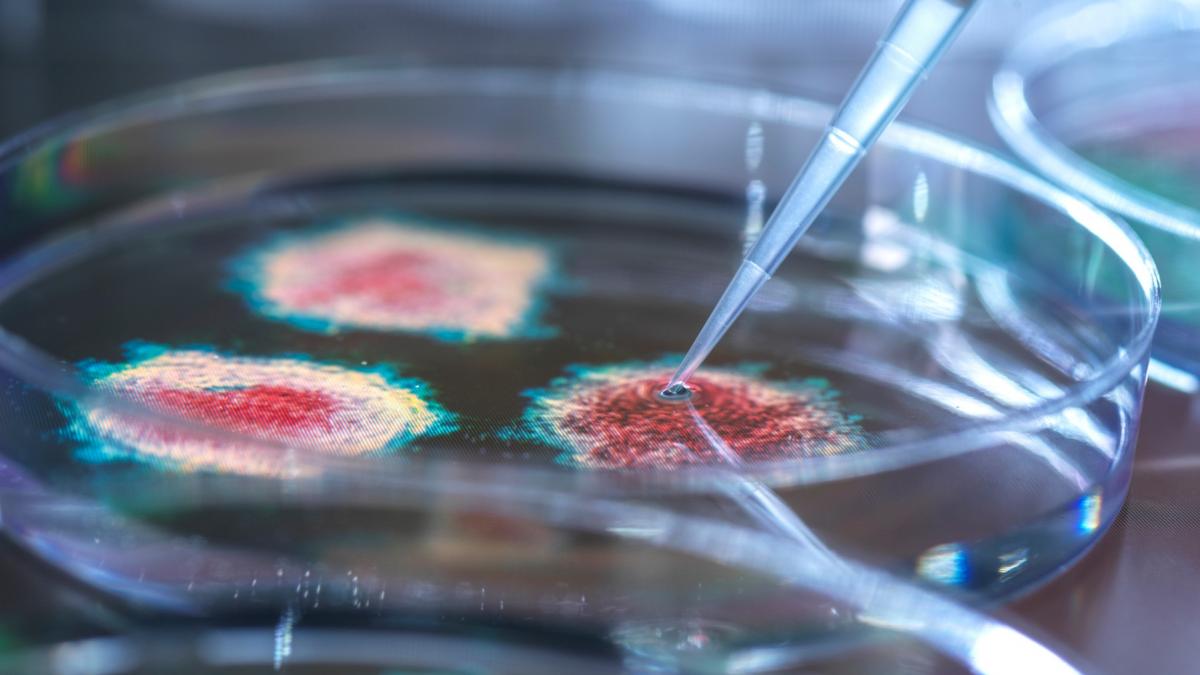
tara in care a fost descoperit un virus care poate ucide superbacteriile oamenii de stiinta spun ca ar putea salva vieti

Antena 3 CNN
›
bacterie rezistentă antibiotice
bacterie rezistentă antibiotice
Eşti pe pagina 1 din 1 a ultimelor ştiri despre bacterie rezistentă antibiotice publicate pe Antena 3.